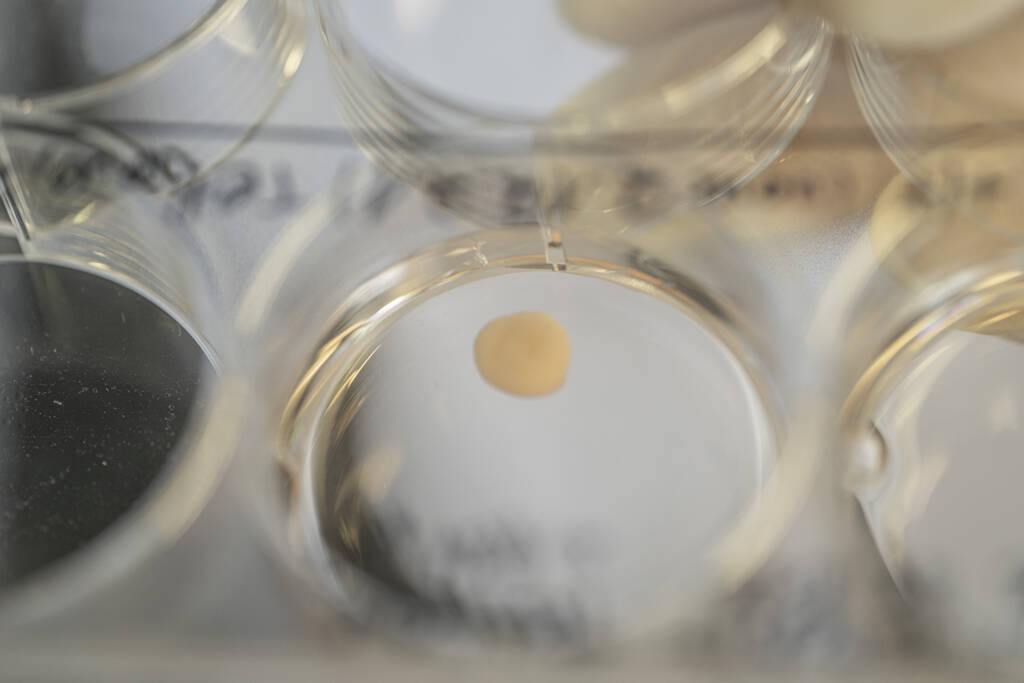
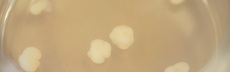
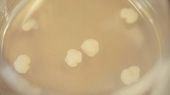

Von der Forschungsfrage bis zur Publikation – Methodenmix in der biomedizinischen Forschung
Methodenmix in der biomedizinischen Forschung Alzheimer auf der Spur – Wie Mini-Organe dabei helfen
Eine Gruppe an der Ruhr-Universität Bochum forscht seit mehr als zehn Jahren an der Volkskrankheit Alzheimer. Die Forscher*innen setzen dabei auf kleine Gewebezellen, die in Petrischalen zu einer Art Mini-Organ heranwachsen – Organoide. Mit deren Hilfe wollen sie einem der Rätsel der Alzheimer-Erkrankung auf die Spur kommen.
Diese Multimedia-Reportage begleitet Dr. Thorsten Müller und sein Team der Arbeitsgruppe Cell Signaling bei einem Alzheimer-Forschungsprojekt.
Die Methoden sind frei
Die Freiheit der Forschung ist in Deutschland im Grundgesetz verankert. Generell können die Forschenden dabei ihre Methoden frei wählen. Wenn Wissenschaftler*innen die Antwort auf eine bestimmte Forschungsfrage suchen, stehen ihnen unterschiedliche Methoden zur Verfügung.
Prinzipiell gibt es viele Wege, um mehr über die Ursachen von Erkrankungen wie Alzheimer zu erfahren – jede Methode hat spezifische Vor- und Nachteile. Um unterschiedliche Aspekte der Erkrankung zu untersuchen, müssen die Forschenden jeweils die geeigneten Methoden anwenden. Die Bochumer Biochemiker*innen haben sich für Arbeit an Organoiden entschieden, um die Grundlagen von Alzheimer zu verstehen.
Tierversuche dürfen nur durchgeführt werden, wenn es dafür keine Alternativmethode gibt. So steht es im Tierschutzgesetz. Sie können unerlässlich sein, um systemische Aspekte von Krankheiten zu untersuchen. Und wenn es später um die Entwicklung von Medikamenten oder Therapien geht, gibt es keine Wahl mehr:
Tierversuche sind dafür gesetzlich vorgeschrieben.
Zur Forschung bitte hier entlang
ÜberblickAuf dem Pfad der Forschung

Volkskrankheit Alzheimer
Volkskrankheit Alzheimer50 Millionen Menschen fehlt die Erinnerung
Mehr als 50 Millionen Menschen sind weltweit von der Erkrankung betroffen. Sie beeinträchtigt schleichend und fortdauernd Gedächtnis, Denken und andere Hirnleistungen wie Sprache, Orientierung oder Urteilsvermögen. Bei manchen Betroffenen verändert sich auch die Persönlichkeit.
Für die Geschichte einfach weiterscrollen oder zurück zur Übersicht.
Nervenzellen sterben ab
Wie kommt es dazu?
Blick ins Alzheimer-Gehirn
Dann passiert folgendes:
Tau-Eiweiße versorgen die Nervenzellen mit Nährstoffen. Kranke Eiweiße verändern sich zu dünnen Fasern in den Zellen. Die Nervenzellen verlieren ihre Form und zerfallen schließlich.
eff
Amyloide
Es ist zwar bekannt, wo diese Eiweiß-Ablagerungen im Gehirn entstehen. Um die Alzheimer-Erkrankung wirksam zu bekämpfen, gilt es jedoch, noch viel mehr über Amyloide in Erfahrung zu bringen.
Verklumpung
Amyloid lässt sich in einem jungen und gesunden Gehirn problemlos abbauen. Doch mit zunehmendem Alter oder erblich bedingt kann sich eine klebrige Beta-Version des Amyloids zwischen den Nervenzellen im Gehirn ansiedeln. Das Eiweiß verklumpt zu unauflöslichen Ablagerungen – den sogenannten Alzheimer-Plaques. In der Folge sterben Nervenzellen und Nervenverbindungen ab.
Tau-Eiweiße versorgen die Nervenzellen mit Nährstoffen. Kranke Eiweiße verändern sich zu dünnen Fasern in den Zellen. Die Nervenzellen verlieren ihre Form und zerfallen schließlich.
Alzheimer-ErkrankungDas große Rätsel
Dazu zählen die Fragen: Sind noch andere Zellen betroffen? Wie entstehen die Ablagerungen? Und vor allem: Wann genau beginnt die Erkrankung überhaupt?
Mit Hilfe von Organoiden sucht das Team um Thorsten Müller nach Antworten.
VIDEO
Privatdozent Dr. Thorsten Müller von der Ruhr-Universität Bochum erklärt, warum er an Alzheimer forscht.
"Wir wollen die Krankheit verstehen!"
Die Wahl der Methode
Gewebezelle oder Tierversuch?Klein, aber oho
Eine der Schwierigkeiten liegt im Zeitablauf der Erkrankung. Die Nervenzellen sterben schleichend ab. Ein Prozess, der mitunter Jahrzehnte dauert. Eine riesige Zeitspanne, die sich zum Beispiel in einer Maus nicht im gleichen Maßstab abbilden lässt. Mäuse leben im Vergleich zum Menschen einfach viel kürzer.
Sind Organoide aus menschlichem Gewebe die Lösung?
VIDEO
Thorsten Müller erklärt, was ein Organoid ist.
"Es entspricht sehr gut dem echten menschlichen Gehirn"
Zellkultur oder Tierversuch?Das eine oder das andere – oder doch beides?
In der Alzheimer-Forschung werden häufig Mäuse, Ratten, Affen oder Zebrafische eingesetzt. Gehirn-Organoide erweisen sich als zunehmend wichtige Ergänzung, um grundlegende Abläufe der Erkrankung zu untersuchen.
Doch längst nicht alle Fragestellungen lassen sich beantworten, wenn Forscher*innen künstliches menschliches Gewebe untersuchen.
VIDEO
Thorsten Müller spricht darüber, bis zu welchem Punkt die Arbeit mit Organoiden sinnvoll ist und ab wann es ohne Tierversuche nicht geht.
Gewebezelle oder Tierversuch?"Bei Medikamenten-Studien kommen wir um Tierversuche nicht herum!"
Zellkultur oder Tierversuch?Das eine oder das andere – oder doch beides?
Thorsten Müller hat in gemeinsamen Forschungsprojekten mit anderen Gruppen gute Erfahrungen mit einem solchen Methodenmix gemacht.
Ein Beispiel hierfür stammt aus der Corona-Forschung: Nachdem die Bochumer Forscher*innen mit Coronaviren infizierte Lungen-Organoide entwickelt hatten, wurden ihre Ergebnisse von Kooperationspartnern in Tierversuchen überprüft.
VIDEO
Thorsten Müller erläutert, warum er große Hoffnung in die Arbeit mit menschlichem Gewebe setzt.
"Wir können direkt mit menschlichem Gewebe arbeiten."
Das Projektteam
Ruhr-Universität BochumWie unterhalten sich Zellen?
Für die Geschichte einfach weiterscrollen oder zurück zur Übersicht.
AG Cell SignalingSie wollen es wissen
PD Dr. Thorsten Müller
Arbeitsgruppenleiter
... koordiniert die Arbeitsgruppe Cell Signaling.
Schreibarbeit
Lisa Bachmann
Doktorandin
... sät die Stammzellen im Labor aus und kultiviert die Organoide mit Nährstoffen.
Hier wird ausgesäht ...
Maite Brachthäuser
Masterstudierende
... untersucht und mikroskopiert die unterschiedlichen Stadien der Organoide.
Unterm Mikroskop ...
David Marks
Doktorand
... schneidet die Organoid-Blöcke und färbt die Organoide an.
Vorbereitung zum Schneiden
Lukas van Impel
Masterstudierender
... untersucht die eingefärbten Organoid-Schnitte am Mikroskop und analysiert die Daten.
Marius Strachowitz
Praktikant
... lernt die Forschung mit Organoiden kennen.
Anfärben des Organoids
Frust oder Freude
Steiniger Weg zur Erkenntnis
Für die Geschichte einfach weiterscrollen oder zurück zur Übersicht.
Herausforderungen in der Organoid-ForschungEine wahre Wundertüte
Dieses Szenario hat Thorsten Müller schon viele Male erlebt.
Vor allem bei der Klonierung – der wesentliche Schritt, um das Amyloid im Gewebe farblich sichtbar zu machen. Dabei wird ein bei Alzheimer mutiertes Gen um ein Gen für ein farblich leuchtendes Eiweiß ergänzt.
Auf diese Weise können die Forscher*innen sehen, welches Organoid eine Alzheimer-Mutation enthält und welches normal wächst. Das Organoid ohne Mutation dient später als Kontrolle.
Herausforderungen in der Organoid-ForschungMonatelange Ungewissheit
Doch es geht auch anders ...
Erfolg in der Organoid-ForschungEndlich eine Antwort!
Wie Thorsten Müller und das Team zur Forschungsfrage gelangen, siehst du hier.
Es gibt aber noch mehr Erfolge ...
VIDEO
Dr. Thorsten Müller beschreibt die erfolgreiche Modellentwicklung.
Ein Beispiel:"Das Modell funktioniert!"
Wie entsteht eine Forschungsfrage?
ForschungsfrageDie nächste bitte!
Zurück zu "Endlich eine Antwort"
Für die Geschichte einfach weiterscrollen oder zurück zur Übersicht.
ForschungsfrageWo entstehen die Ablagerungen?
Aktuell wollen die Bochumer Wissenschaftler*innen herausfinden, zu welchem Zeitpunkt Veränderungen, genauer gesagt Amyloid-Ablagerungen, im menschlichen Gehirn entstehen. Warum sehen wir sie in bestimmten Zellen, in anderen Zellen nicht? Welche Zellen sind betroffen?
Thorsten Müller und sein Team haben da etwas in einem Alzheimer-Organoid entdeckt.
Die Frage aller FragenWelche Veränderungen bewirkt eine Alzheimer-Mutation in Organoiden?
Wie kann man die Pathologie der Zellen beeinflussen und daraus später Therapieansätze entwickeln?
Die Forscher*innen wollen mit ihrer Arbeit dazu beitragen, die Antwort darauf zu finden. Bis dahin ist es noch ein langer Weg.
Denn bevor es ins Labor geht, liegt noch viel Schreibtischarbeit vor Thorsten Müller.
Entstehung eines ForschungsprojektesViel Schreibarbeit ...
Zurück zum Team? Hier entlang...
Forschungsfrage... und noch mehr Geduld
In dem Antrag legt er unter anderem dar, welche Erkenntnisse, Hypothesen und Ideen sich aus der bisherigen Arbeit seines Teams ergeben haben und welchen Nutzen seine Forschungsergebnisse versprechen.
Bis zu einer Entscheidung über die Bewilligung der Fördermittel vergeht schon mal mehr als ein halbes Jahr. Langweilig wird ihm in dieser Zeit dennoch nicht. Andere Projekte erfordern seine Aufmerksamkeit.
Das Projekt
ForschungsprojektAuf ins Labor ...
Für die Geschichte einfach weiterscrollen oder zurück zur Übersicht.
DifferenzierungVon der Stammzelle zur Nervenzelle
Differenzieren ... Was passiert da?
DifferenzierungVon der Stammzelle zur Nervenzelle
Schritt 1: Aussaat des Organoids 9000 Zellen Saatgut
Damit die Zellen sich gut entwickeln, versorgt eine spezielle Lösung diese mit wichtigen Nährstoffen. Diese Zellen sind ungefähr 50 Mikrometer (0,05 Millimeter) klein. Zum Vergleich: Ein menschliches Haar hat einen Durchmesser von etwa 100 Mikrometern.
Nun kann die Differenzierung beginnen ...
Zurück zum Team? Hier entlang...
Schritt 1: Aussaat des OrganoidsTraubenzucker am Wochenende
Geschüttelt, nicht gerührt!
Organoid reinigenAbschied von den toten Zellen
Anschließend legen sie das gesäuberte Organoid in ein Matrigel. Diese Gelee-artige Substanz stützt den bis einen Zentimeter kleinen Körper des Organoids wie eine Art Korsett. Es hilft dabei, dass sich die Strukturen des Organoids weiter spezialisieren und entwickeln.
Schritt 2Ran ans Mikroskop ...
... und gucken, ob's was wird.
Schritt 2: Beobachtung am MikroskopEs wächst und gedeiht
Wie das genau aussieht, siehst du auf den nächsten Seiten.
Die ersten Rundungen
Rund um das Organoid befinden sich noch tote Zellen, die nun herausgewaschen werden.
Zurück zu "Abschied von den toten Zellen"
Tag 7
Gesund vs. krank
Der Vergleich ist ein vorbereitender Schritt und dient der Kontrolle: Das Team beobachtet das Wachstum der beiden Varianten. Im Idealfall weisen beide Organoide zu diesem Zeitpunkt keine bedeutenden Unterschiede in der Größe auf. Das ist sehr wichtig, denn die genetische Veränderung sollte keinen Einfluss auf das Wachstum haben. Dies würde den Vergleich der beiden Varianten verfälschen.
Das ist hier der Fall! Das Wildtyp-Organoid entwickelt sich genauso wie das Kontroll-Organoid ohne Gen-Mutation. Das ist wichtig für die weitere Arbeit. Jetzt kann das Team mit den eigentlichen Untersuchungen beginnen. Es geht um die Frage, was die eingeführte Mutation (PSEN1) im Gewebe verändert.
Tag 4
Tag 6
Tag 11
Wildtyp-Organoid
Der Wildtyp (WT) weist keinerlei Gen-Veränderungen auf.
Alzheimer-Organoid
PSEN1 ist aus einer Stammzelllinie hergestellt, die die sogenannte
"Presenilin1"-Mutation trägt. Dies ist eine der Mutationen, die zu starken Alzheimer-Symptomen führen. Betroffene Patient*innen
erkranken schon sehr früh an Demenz. Deshalb ist ein Organoid mit dieser Mutation ein sehr gutes
Modell, um die Mechanismen der Erkrankung untersuchen zu können.
Was sehen wir in diesem Vergleich?
Zur Erinnerung: Es ist wichtig, dass die Organoide keine großen Unterschiede im Wachstum zeigen – sonst wird der Vergleich der beiden Organoid-Typen später schwierig.
Das ist hier der Fall! Das Wildtyp-Organoid entwickelt sich genauso wie das Kontroll-Organoid ohne Gen-Mutation. Das ist wichtig für die weitere Arbeit. Jetzt kann das Team mit den eigentlichen Untersuchungen beginnen. Es geht um die Frage, was die eingeführte Mutation (PSEN1) im Gewebe verändert.
Tag 11
Tag 15
Tag 19
Tag 21
Amyloid-Ablagerungen untersuchen. Das Gewebe hat nun einen Durchmesser von fast 2 Millimetern.
Schritt 3Scharfe Schnitte
Was da passiert? Einfach weiterscrollen!
Zurück zum Team? Hier entlang...
Schritt 3: Scharfe SchnitteTrennung in vollem Gange
Doch bevor er es in die schwarze Gitterform gibt, braucht er eine Flüssigkeit, in die er das Organoid legen kann.
Schritt 3: Vorbereitung des SchnittesRüttelpartie bei 45 Grad
Bereit für den Schnitt
Organoid-Block
Schneidemesser
Eis zum Kühlen
Schraube zum Fixieren
Vibratom-Knöpfe
Schritt 4: Daten sammelnHightech und bunte Farben
Zurück zum Team? Hier entlang...
Zurück zu "Schreibarbeit und Geduld"
Schalter ein? Schalter aus?
Die Alzheimer-Mutation im Gehirn-Organoid führt schon sehr für zu vermehrten Ablagerungen, weil bestimmte Gene in bestimmten Zellen angeschaltet und in anderen abgeschaltet sind.
Diese Vermutung überprüft das Team nun in einem langen Prozess. Wie machen sie das?
Daten auslesenEinfärbung unterschiedlicher Proteine
Die Bilder auf dem Monitor erinnern an bunt eingefärbte Korallen. Was dort leuchtet, sind jedoch die unterschiedlichen Eiweiße im Gehirn-Organoid.
Mit Hilfe des Konfokal-Mikroskops lassen sich sogar die einzelnen Ebenen des Organoids miteinander vergleichen.
Aufbauend auf Forschungsfrage und Hypothesen können die Forscher*innen nun bestimmte Kenngrößen messen. Ein wichtiger Schritt hin zum Ergebnis, den die Wissenschaftler*innen als „Quantifizierung“ bezeichnen.
ZwischenergebnisQuantifi..., was?
Für die Organoide heißt das zum Beispiel:
Wie viele Nervenzellen werden mit einer bestimmten Farbe markiert?
Die Forscher*innen färben bei dem gesunden Organoid und dem Alzheimer-mutierten Organoid die gleichen Typen von Nervenzellen an, eine Software zählt dann die eingefärbten Zellen auf jedem Bild.
Die Werte vergleichen sie dann und gelangen zu einem ersten Zwischenergebnis. Wie der Vergleich aussieht und was die Forscher*innen daraus schließen, siehst du auf den nächsten Seiten:
Das Zwischenergebnis
Die Messung hat ergeben:
In den Alzheimer-Organoiden sind viel mehr neuronale Vorläuferzellen vorhanden als in den gesunden Organoiden, die der Kontrolle dienen. Daraus schließen Thorsten Müller und sein Team, dass die Alzheimer-Organoide in ihrer Entwicklung verzögert sind.
Wie sich das kranke und gesunde Organoid unter dem Mikroskop an unterschiedlichen Tagen jeweils verändern, siehst du auf der nächsten Seite:
Blaue Markierung: Zellkerne
Rote Markierung: Reife Nervenzellen
Das Alzheimer-Organoid hingegen besitzt an einigen Stellen noch Vorläuferzellen – gut erkennbar an den grün gefärbten Ansammlungen.
Tag 28/29
Tag 34/35
Tag 40
Wildtyp-Organoid
Der Wildtyp (WT) weist keinerlei Gen-Veränderungen auf.
Alzheimer-Organoid
Zur Erinnerung: PSEN1 ist aus einer Stammzelllinie entstanden, die eine so genannte
"Presenilin1"-Mutation trägt. Diese Mutation führt zu starken Alzheimer-Symptomen.
Vergleich an Tag 28/29
Beim Alzheimer-Organoid sehen wir viele grün markierte Punkte. Dies sind die neuronalen Vorläuferzellen – die Vorstufe zu reifen Nervenzellen.
Grüne Markierung: Neuronale Vorläuferzellen
Blaue Markierung: Zellkerne
Rote Markierung: Reife Nervenzellen
Vergleich Tag 34 bis 40
Im gesunden Organoid sind fast ausschließlich reife Nervenzellen und Zellkerne zu sehen – die blau und rot gefärbten Zellen sind dominierend.
Das Alzheimer-Organoid hingegen besitzt an einigen Stellen noch Vorläuferzellen – gut erkennbar an den grün gefärbten Ansammlungen.
Bunt wie ein Feuerwerk

Blau = Zellkerne (speichern u.a. die genetischen Informationen)
Grün = Neuronale Vorläuferzellen (aus jeder dieser Zellen entwickeln sich im weiteren Wachstumsprozess neue Zellen, u.a. Nervenzellen)
Anhand der Vorher/Nachher-Ansicht kannst du dir die unterschiedlichen Farben anschauen.
ZusammenfassungWas bedeutet das jetzt?
Für die Forschung bietet dies neue Perspektiven:
Erstmals können die ganz frühen Mechanismen in einem menschlichen Modell untersucht werden. Bislang konnten Wissenschaftler*innen diese Zusammenhänge nur am Tiermodell, z.B. an Mäusen, erforschen.
Wenn diese frühen Mechanismen verstanden sind, können die Forscher*innen mit ihrem neuen Organoid-Modell vielleicht neue Ansätze für Therapeutika finden.
Grenzen eines Organoids
Gegenwart und Zukunft der OrganoideBis hierhin und nicht weiter
Es stellt sich die Frage, ob Organoide eines Tages in der Lage sein werden, Tierversuche komplett zu ersetzen. Mit dieser Frage befassen sich auch die Bochumer Forscher*innen täglich. In absehbarer Zeit erscheint ein solcher Schritt trotz aller Fortschritte dieser jungen Methode noch nicht möglich.
Für die Geschichte einfach weiterscrollen oder zurück zur Übersicht.
Ende von Tierversuchen?Viel Potenzial – aber nicht in allen Bereichen
Thorsten Müller glaubt dennoch, dass Organoide das Potenzial haben, zunehmend an die Stelle von Tierversuchen zu treten, sowohl in Bereichen der Grundlagenforschung als auch beim Testen von Medikamenten. In anderen Bereichen bilden Organoide bereits im Methodenmix eine gute Ergänzung zum Tierversuch.
VIDEO
Dr. Thorsten Müller sieht noch Luft nach oben.
Standard-Frage"Das Blutgefäßsystem können wir in den Organoiden noch nicht entwickeln."
Nährstoffversorgung bricht ab – die Zellen sterben
Und dann gibt es da noch ein Versorgungsproblem: Organoide besitzen kein Blutgefäßsystem. Somit gelangen die Nährstoffe nach einiger Zeit nicht mehr bis in das Innere des Gewebes. Dadurch sterben die innersten Zellen ab – das Organoid wird hohl.
AUDIO
Thorsten Müller spricht über die Möglichkeiten, Organoide als Assembloide miteinander zu kombinieren.
AssembloideIn Verbindung kommen
Zurück zu "Viel Potenzial – aber nicht in allen Bereichen"
ZusammengefasstWann eignen sich Organoide nicht als Ersatz für Tierversuche?
Organoide sind nicht eingebettet in den lebenden Organismus. Damit fehlt ihnen die Versorgung durch Blutgefäße und die Verbindung zu Nervenzellen, etwa zu den Zellen des Nerven- und des Immunsystems. Somit können Organoide die Komplexität des lebenden Organismus aktuell nicht vollständig abbilden.
VIDEO
Dr.
Thorsten Müller will künftig mehr ins Detail der Zelle gehen.
Blick in die ZukunftWie geht es weiter?
Die Publikation
PublikationEchte Teamarbeit
Bis zu einem Gesamtergebnis des Projektes dauert es noch einige Monate. Thorsten Müller schätzt, dass die Publikation Ende des Jahres 2022 veröffentlicht werden kann. Die Ergebnisse sollen schließlich einen Mehrwert bieten. Für die Öffentlichkeit und andere Wissenschaftler*innen – für weitere Forschung.
Wenn es soweit ist heißt es: ganz viel Teamarbeit! Die Doktorand*innen steuern jetzt ihre Beiträge dazu bei. Es gilt, die angewandten Methoden zu erläutern und die „quantifizierten“ Ergebnisse zu diskutieren.
Die Bochumer Forscher*innen erzählen ihre Geschichte von der Forschungsidee zum Ergebnis.
Für die Geschichte einfach weiterscrollen oder zurück zur Übersicht.
PublikationDer letzte Schritt ...
PublikationNach dem Projekt ist vor dem Projekt
Auf Thorsten Müller und sein Team warten indes schon die nächsten Fragen, die es zu beantworten gilt. Nach dem Projekt ist vor dem Projekt. Die abgeschlossene Versuchsreihe hat neue Fragestellungen aufgeworfen. Das Team diskutiert Ideen, wie sich diese Fragen mit Hilfe von Organoiden beantworten lassen.
Tage oder Wochen später schaltet Thorsten Müller seinen Computer an. Die Tastatur klappert unter seinen Fingern. Auf dem Bildschirm erscheint das Wort "Antrag".
Methodenmix in der biomedizinischen ForschungVon der Forschungsfrage bis zur Publikationmmm

Alzheimer auf der Spur – Wie Mini-Organe dabei helfen
Alzheimer auf der Spur – Wie Mini-Organe dabei helfen
 Die Methoden sind frei
Die Methoden sind frei
 Auf dem Pfad der Forschung
Auf dem Pfad der Forschung
 50 Millionen Menschen fehlt die Erinnerung
50 Millionen Menschen fehlt die Erinnerung
 Nervenzellen sterben ab
Nervenzellen sterben ab
 Blick ins Alzheimer-Gehirn
Blick ins Alzheimer-Gehirn
 "Wir wollen die Krankheit verstehen!"
"Wir wollen die Krankheit verstehen!"
 Klein, aber oho
Klein, aber oho
 Klein, aber oho
Klein, aber oho
 "Es entspricht sehr gut dem echten menschlichen Gehirn"
"Es entspricht sehr gut dem echten menschlichen Gehirn"
 Das eine oder das andere – oder doch beides?
Das eine oder das andere – oder doch beides?
 "Bei Medikamenten-Studien kommen wir um Tierversuche nicht herum!"
"Bei Medikamenten-Studien kommen wir um Tierversuche nicht herum!"
 Das eine oder das andere – oder doch beides?
Das eine oder das andere – oder doch beides?
 "Wir können direkt mit menschlichem Gewebe arbeiten."
"Wir können direkt mit menschlichem Gewebe arbeiten."
 Wie unterhalten sich Zellen?
Wie unterhalten sich Zellen?
 Sie wollen es wissen
Sie wollen es wissen
 PD Dr. Thorsten Müller
PD Dr. Thorsten Müller
 Lisa Bachmann
Lisa Bachmann
 Maite Brachthäuser
Maite Brachthäuser
 David Marks
David Marks
 Lukas van Impel und Marius Strachowitz
Lukas van Impel und Marius Strachowitz
 Steiniger Weg zur Erkenntnis
Steiniger Weg zur Erkenntnis
 Eine wahre Wundertüte
Eine wahre Wundertüte
 Monatelange Ungewissheit
Monatelange Ungewissheit
 "Das Modell funktioniert!"
"Das Modell funktioniert!"
 Die nächste bitte!
Die nächste bitte!
 Wo entstehen die Ablagerungen?
Wo entstehen die Ablagerungen?
 Die Forschungsfrage
Die Forschungsfrage
 Die Frage aller Fragen
Die Frage aller Fragen
 Viel Schreibarbeit ...
Viel Schreibarbeit ...
 ... und noch mehr Geduld
... und noch mehr Geduld
 Auf ins Labor ...
Auf ins Labor ...
 Von der Stammzelle zur Nervenzelle
Von der Stammzelle zur Nervenzelle
 9000 Zellen Saatgut
9000 Zellen Saatgut
 Traubenzucker am Wochenende
Traubenzucker am Wochenende
 Geschüttelt, nicht gerührt!
Geschüttelt, nicht gerührt!
 Abschied von den toten Zellen
Abschied von den toten Zellen
 Ran ans Mikroskop ...
Ran ans Mikroskop ...
 ... und gucken, ob's was wird.
... und gucken, ob's was wird.
 Es wächst und gedeiht
Es wächst und gedeiht
 Die ersten Rundungen
Die ersten Rundungen
 Tag 7
Tag 7
 Gesund vs. krank
Gesund vs. krank
 Tag 11
Tag 11
 Tag 15
Tag 15
 Tag 19
Tag 19
 Tag 21
Tag 21
 Scharfe Schnitte
Scharfe Schnitte
 Trennung in vollem Gange
Trennung in vollem Gange
 Rüttelpartie bei 45 Grad
Rüttelpartie bei 45 Grad
 Einfüllen Agarose in Gitterform
Einfüllen Agarose in Gitterform
 Organoid-Block unter der Lupe
Organoid-Block unter der Lupe
 Entfernung des Blockes aus der Gitterform
Entfernung des Blockes aus der Gitterform
 Festkleben Organoid
Festkleben Organoid
 Nahaufnahme des Organoid-Blockes
Nahaufnahme des Organoid-Blockes
 Bereit für den Schnitt
Bereit für den Schnitt
 Vibratom mit Organoid-Block
Vibratom mit Organoid-Block
 Vibratom-Knöpfe
Vibratom-Knöpfe
 Schnitt des Organoids
Schnitt des Organoids
 Einbetten des Organoid-Schnittes
Einbetten des Organoid-Schnittes
 Hightech und bunte Farben
Hightech und bunte Farben
 Schalter ein? Schalter aus?
Schalter ein? Schalter aus?
 Einfärbung unterschiedlicher Proteine
Einfärbung unterschiedlicher Proteine
 Quantifi..., was?
Quantifi..., was?

 Bunt wie ein Feuerwerk
Bunt wie ein Feuerwerk
 Was bedeutet das jetzt?
Was bedeutet das jetzt?
 Bis hierhin und nicht weiter
Bis hierhin und nicht weiter
 "Das Blutgefäßsystem können wir in den Organoiden noch nicht entwickeln."
"Das Blutgefäßsystem können wir in den Organoiden noch nicht entwickeln."
 Nährstoffversorgung bricht ab – die Zellen sterben
Nährstoffversorgung bricht ab – die Zellen sterben
 In Verbindung kommen
In Verbindung kommen
 Wie geht es weiter?
Wie geht es weiter?
 Echte Teamarbeit
Echte Teamarbeit
 Der letzte Schritt ...
Der letzte Schritt ...
 Nach dem Projekt ist vor dem Projekt
Nach dem Projekt ist vor dem Projekt
 Von der Forschungsfrage bis zur Publikation
Von der Forschungsfrage bis zur Publikation

 Schreiben und Forschen
Schreiben und Forschen